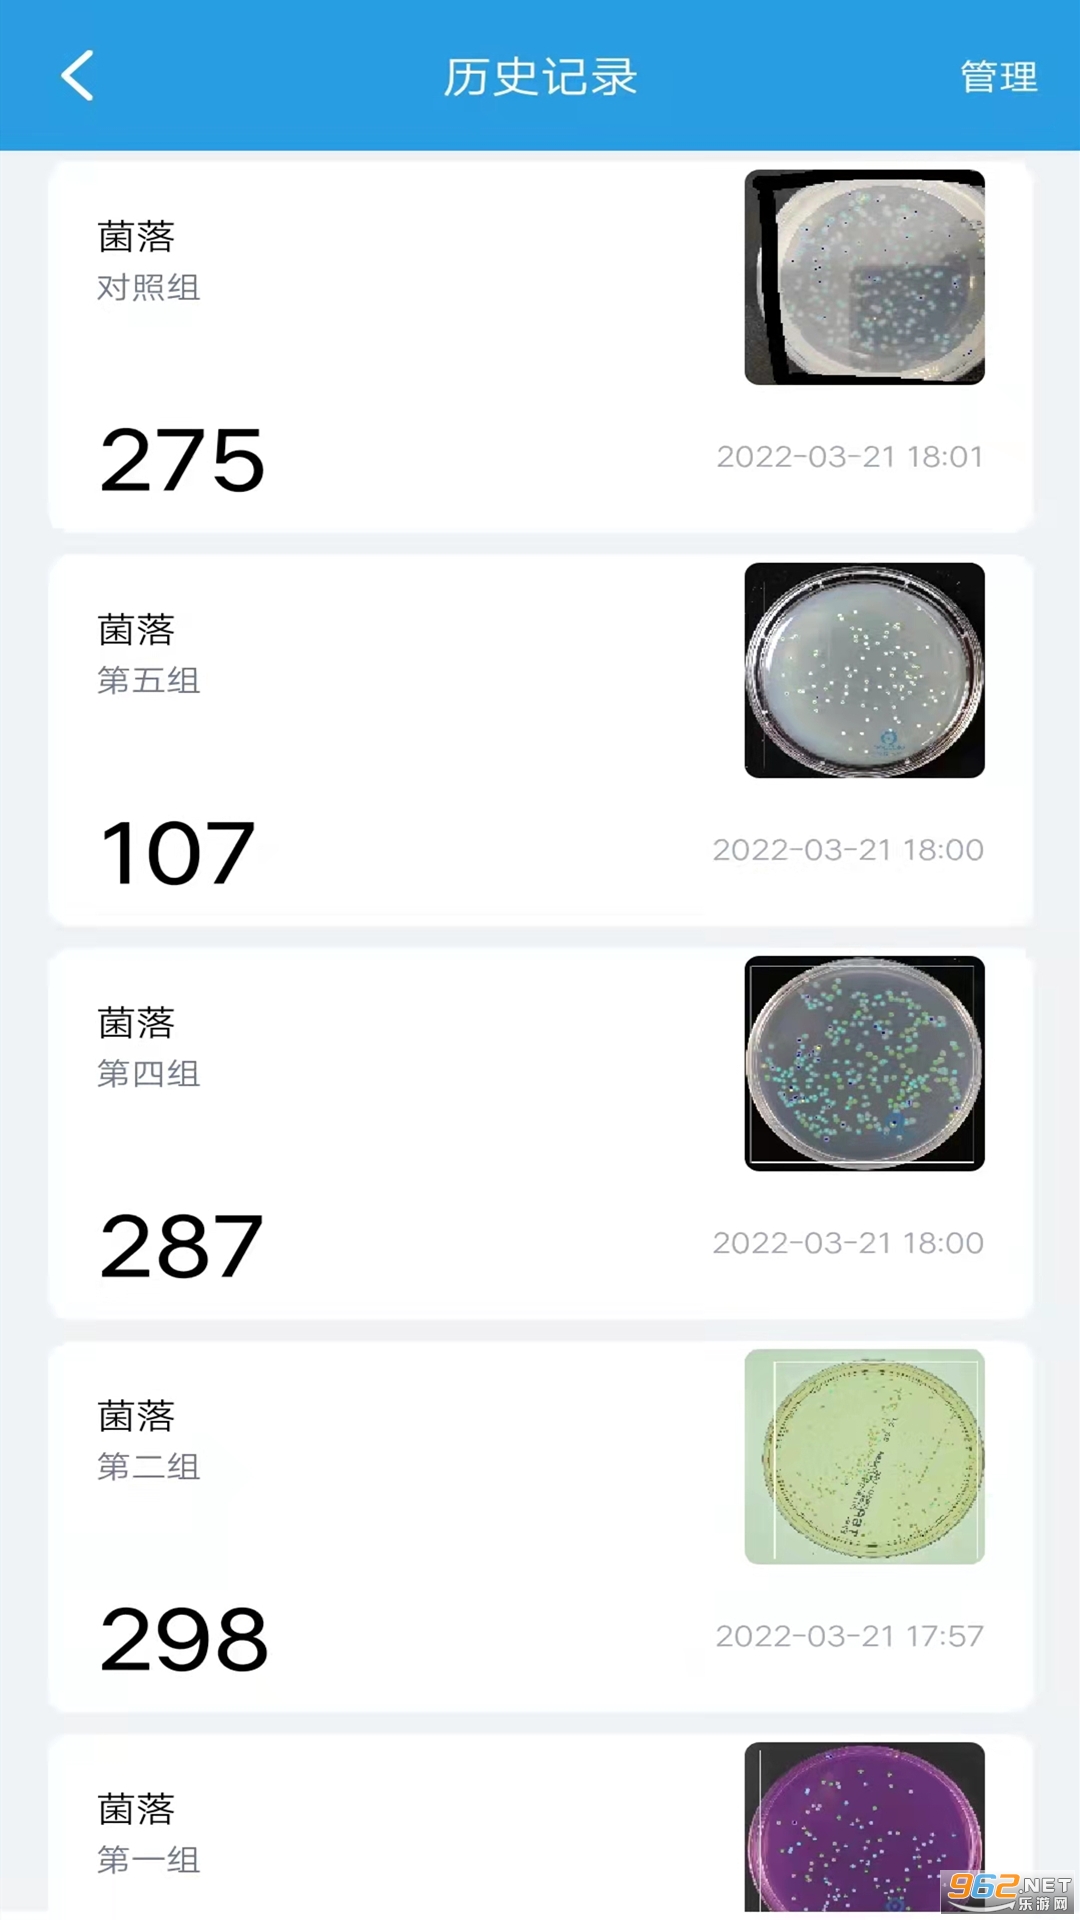

《精点相机》是一款功能强大的点数相机软件,提供多种不同领域的模板,包括工业、生物医学、养殖、农林等等。用户可以根据自己的需求选择相应的模板,在一键拍照的同时快速准确地查找和点数物品。相较于传统的人工数数方法,精点相机不仅速度快,还能提高准确率,为用户带来极大的便利和效率。
精点相机是免费的吗
精点相机是一款免费的拍摄软件,它的所有功能和模板库都是免费的,包括但不限于拍照和从相册选择的识别方式、人工纠正功能、不断更新的模板库、多种物品同时统计功能、区域圈选功能、历史记录功能等。此外,对于物体尺寸也没有要求,用户可以根据需要选择不同尺寸的物品进行统计。因此,可以说精点相机的使用是不需要支付费用的。
精点相机怎么样
1.图片背景无要求。传统的图像识别对图片背景有非常严格的要求,只能在纯色背景下进行识别。精密点相机采用新一代人工智能计数,对画面背景无要求
2.对图像碎片坑有较强的干扰。它可以很容易地识别复杂图像中的目标物体,并对其他碎片干扰具有很强的滤波效果
3.多分类统计,可以对多个分类项目进行一次性统计,并计算每个分类项目的数量
4.对物品的大小没有要求,各种大小的物品都可以因大小差异而无误地计数
精点相机怎么使用
1.在本站点击下载精点相机APP,安装以后打开应用
2.使用APP之前,需要先注册登录,登录后进入APP首页
3.在模板界面,找到并下载菌落点数对应模板
4.接下来,只需要对着培养皿拍照,圈选点数范围即可
5.最后点击识别,等待几秒钟,即可完成点数了
精点相机怎么收费的啊
精点相机则按使用次数计费,免费赠送了100次,并且有免费次数机会。
小编点评
精点相机是一款非常实用的相机软件,能够帮助用户迅速进行物品的点数和查找。其提供的多种模板选择,覆盖了不同领域,满足了用户的多样化需求。通过一键拍照,用户可以快速准确地完成物品的点数工作,大大提高了工作效率。相比传统的人工数数方法,精点相机不仅速度更快,还能提高准确率,减少了人为错误的可能性。


 得间免费小说app
得间免费小说app 黑岩阅读
黑岩阅读 番茄小说
番茄小说 影视仓tv99内置盒子版
影视仓tv99内置盒子版 计算器应用锁
计算器应用锁 影视仓去除内置广告
影视仓去除内置广告 酷漫星漫画
酷漫星漫画 中国篮球软件
中国篮球软件 腾讯体育视频直播app
腾讯体育视频直播app 影视仓去广告版
影视仓去广告版 QQ音乐小米版
QQ音乐小米版 海心医生手机版
海心医生手机版

Terabox
Terabox Via浏览器国际版
Via浏览器国际版 开拍Action
开拍Action
 悦颜视频美颜
悦颜视频美颜
 甜盐相机
甜盐相机
 soda相机
soda相机
 工作蜂相机
工作蜂相机
 荣耀扫名片
荣耀扫名片
 照片美图拼图
照片美图拼图
 相机P图
相机P图
 照片拼图师
照片拼图师
 PS软件P图
PS软件P图
 XMEye监控眼
XMEye监控眼
 TrueShot
TrueShot
 彩豆水印相机
彩豆水印相机
 FaceJoy
FaceJoy
 微脉水印相机
微脉水印相机
 易力奥摄像头app(ComOne)
易力奥摄像头app(ComOne)
 智能证件照相机(PhotoMaker)
智能证件照相机(PhotoMaker)
 精英证件照(PhotoMaker)
精英证件照(PhotoMaker)
 速记相机
速记相机
 证件照相机
证件照相机
 甜美特效相机
甜美特效相机
 潮颜相机
潮颜相机
 美妆相机
美妆相机
 vivo内置相机
vivo内置相机
 浙邮惠商户版
浙邮惠商户版 todesk手机版
todesk手机版 Spotify软件
Spotify软件 小米浏览器
小米浏览器 新加坡打车软件grab中文版
新加坡打车软件grab中文版 马来西亚打车软件app
马来西亚打车软件app 谷歌图书
谷歌图书 谷歌电子书阅读器
谷歌电子书阅读器 闪速浏览器
闪速浏览器 语音王app
语音王app 安卓彩蛋
安卓彩蛋 闪速浏览器手机版
闪速浏览器手机版 儿时的街机游戏
儿时的街机游戏
 拼图游戏大全
拼图游戏大全
 原神
原神
 生活实用APP
生活实用APP